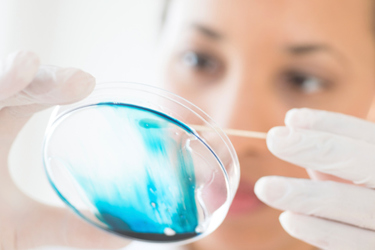

Can Cell Therapies Help Save Big Pharma From The Patent Cliff?
By Karine Kleinhaus, MD, MPH, Divisional VP, North America, Pluristem Therapeutics
A substantial number of large pharmaceutical companies are facing a “patent cliff”, as many blockbuster drugs begin going off-patent. Companies manufacturing generic drugs have already stepped in or are set to enter into markets that have been previously dominated by these blockbusters. One well known example of this is the 2011 arrival of generic versions of Atorvastatin, which had been marketed by Pfizer under the trade name Lipitor. From 1996 to 2012 Lipitor became the world's best-selling drug of all time, with over $125 billion in total sales (1). Sales plummeted as generics from several manufacturers burst into the market when Lipitor went off patent in 2011. Other blockbuster drugs that have gone off patent in the last decade and more will follow soon. As a result, big pharmaceutical companies must develop, out-license, or acquire therapies that target important indications and which are protected by strong patents for extended periods of time.
One exciting place for pharmaceutical companies to look for new, patent-protected treatments is within new fields of biologic therapies. Cell therapy is a major emerging class of new and innovative biologics. Cell therapy is the administration of intact, living cells into a patient. While blood transfusion and bone marrow transplantation are well established, the term cell therapy is often used to refer to a developing field in which a variety of cells are administered to treat disease or repair dysfunctional or injured tissue. Cell therapy products by and large are in development and have yet to enter the U.S. market. There are multiple ongoing clinical trials, both early and late stage, and interest is mounting in cell therapy’s potential to address unmet medical need for a variety of chronic conditions. Many chronic conditions are associated with old age and diabetes. As populations age, the prevalence of these conditions is expected to increase significantly; consequently, the market for therapies that address related indications are predicted in aggregate to be worth billions of dollars.
Cell therapies can be characterized or classified in different ways. One common approach is to divide the therapies into autologous and allogeneic therapies. Specific cells can be harvested from a patient and re-administered after expansion and purification or modification (autologous therapy), or they can be sourced from other people and then expanded and modified into therapeutic products that can be used in multiple patients (allogenic therapy). The business models differ sharply for these two types of approaches, and there are advantages and disadvantages to each approach.
In autologous cell therapy, a patient must undergo an invasive procedure to harvest his or her own cells. Then, they must wait for the expansion and processing of those cells before returning to a clinician for re-administration of the cells. Disadvantages to this approach include the need for an invasive procedure to harvest a patient’s cells, a minimum of two required visits, questions about reimbursement and barrier to entry, and the slim room for error in processing the cells since any missteps can require the process to begin again. Similarly, the cells are often not sufficiently altered to be patentable. On the other hand, in some cases when the processing of the cells is minimal, all that is needed to enter the market is FDA approval of the device that does the processing. Approval of a device can be a simpler and shorter formula than approval of a new therapeutic. When cells are altered sufficiently, the FDA considers them a therapeutic that needs to be approved through the same pathways as other new treatments, creating the need for multiple randomized trials.
However, the business model for allogeneic therapy has some major advantages. Allogeneic therapies can be patented because they are considered new products. The technology required to develop them and manufacture them can be so intricate that, even without good patent protection, the barrier to entry into the cell therapy space by a biosimilar could be expected to be extremely high. Allogeneic cell therapies are often off-the-shelf, meaning that no matching is required for cells to be given to a patient. The cells can be manufactured off-site, stored at point-of-care, and administered non-invasively by a physician in one visit. The cells could be available to treat acute conditions such as heart attack or stroke, which would not generally be the case for autologous therapies. These characteristics make the allogeneic approach attractive to large pharmaceutical companies looking to replenish their pipelines.
Allogeneic cell therapy companies are targeting many important unmet medical needs, including critical limb ischemia and other types of peripheral artery disease, hematologic indications, orthopedic indications, ischemic stroke, and ischemic heart disease. In addition to the advantages of allogeneic cell therapy described earlier, this broad market potential makes allogeneic cell therapy particularly attractive to large pharmaceutical companies. A key to success with these cell products, both in the clinical trial stage and at commercialization, is the ability to precisely and reliably manufacture the cells in large, homogeneous batches using a patented technology that can be easily scaled up to meet increasing demand. Drug companies will likely need to consider this capability when looking for partners in the cell therapy space. Cells are sensitive creatures, and even small changes in manufacturing processes can modify their characteristics and affect their functionality. Regulatory agencies as well are likely to require cell companies to demonstrate that their manufacturing methods remain consistent if they scale up to meet the demand of larger trials and commercialization; if the methods need to be adapted significantly because of issues with production, the cells may differ from those that were manufactured earlier in the development process.
As many blockbuster drugs go off patent, large pharmaceutical companies need to fill their pipelines with new, innovative therapies that can be patented for long-term protection and that address indications with substantial market potential. Allogeneic cell therapy products could fit this bill. As the development of these cell products progresses, with additional data and successful mid- and late-stage trials, one can expect to see more partnerships between Big Pharma and emerging biotechnology companies in the cell therapy arena.
(1)"Lipitor becomes world's top-selling drug". Crain's New York Business. 2011-12-28.